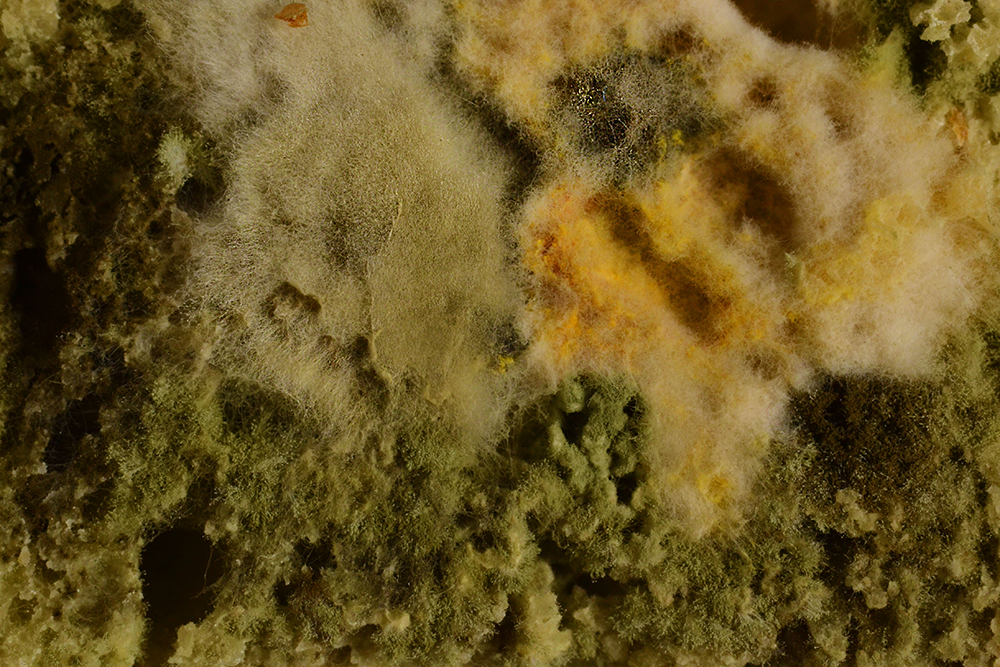

Prises micro-photographiques d'une petite expérience scientifique de développement de moisissures Rhizopus sur des échantillons de banane, pain et cactus.




Gravures à la pointe seiche sur plexiglass et impressions à la presse manuelle.
format papier 20cm², gravures 5cm²
format papier 20cm², gravures 5cm²